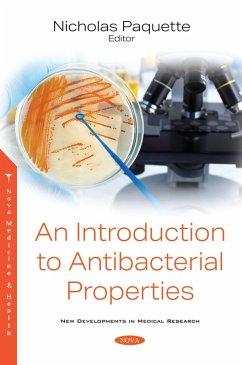

Introduction to Antibacterial Properties (eBook, PDF)
PAYBACK Punkte
45 °P sammeln!
An Introduction to Antibacterial Properties provides an overview of the current antibacterial techniques and main strategies being employed for controlling the colonisation of bacteria on surfaces, together with the design of antibacterial surfaces and their fabrication techniques. The authors discuss the characteristic mechanisms of five main aspects of antibacterial agents and the corresponding representative type of antibacterial agents. In addition, recent findings in (meth)acrylate hydrogels containing metal ions with antimicrobial properties are summarized. Antibiotics, commonly referred...
An Introduction to Antibacterial Properties provides an overview of the current antibacterial techniques and main strategies being employed for controlling the colonisation of bacteria on surfaces, together with the design of antibacterial surfaces and their fabrication techniques. The authors discuss the characteristic mechanisms of five main aspects of antibacterial agents and the corresponding representative type of antibacterial agents. In addition, recent findings in (meth)acrylate hydrogels containing metal ions with antimicrobial properties are summarized. Antibiotics, commonly referred to as "wonder drugs", have been used for various therapeutic purposes for decades. As such, this compilation addresses a concomitant problem: the emergence of drug resistance. Antimicrobial adjuvants can aid in the prevention of antimicrobial resistance by suppressing the emergence of bacterial resistance and rejuvenating the antimicrobial activity of currently available commercial antibiotics cost-effectively.
Dieser Download kann aus rechtlichen Gründen nur mit Rechnungsadresse in A, B, BG, CY, CZ, D, DK, EW, E, FIN, F, GR, HR, H, IRL, I, LT, L, LR, M, NL, PL, P, R, S, SLO, SK ausgeliefert werden.